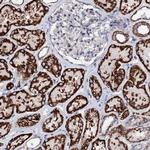
FAM115C Antibody in Immunohistochemistry (Paraffin) (IHC (P))

Search
Invitrogen
FAM115C Polyclonal Antibody
{{$productOrderCtrl.translations['antibody.pdp.commerceCard.promotion.promotions']}}
{{$productOrderCtrl.translations['antibody.pdp.commerceCard.promotion.viewpromo']}}
{{$productOrderCtrl.translations['antibody.pdp.commerceCard.promotion.promocode']}}: {{promo.promoCode}} {{promo.promoTitle}} {{promo.promoDescription}}. {{$productOrderCtrl.translations['antibody.pdp.commerceCard.promotion.learnmore']}}
产品信息
PA5-58529
种属反应
宿主/亚型
分类
类型
抗原
偶联物
形式
浓度
规格
纯化类型
保存液
内含物
保存条件
运输条件
RRID
产品详细信息
Immunogen sequence: WLARGQTGKV GVNTNLKDLC PLLSEHGLQC SLEPHLNSDL CVYCCKAYSD KEAKQLQEFV AE
Highest antigen sequence identity to the following orthologs: Mouse - 68%, Rat - 61%.
靶标信息
The FAM115C gene (Family with Sequence Similarity 115 Member C) is a relatively under-characterized gene located on chromosome 9q34.13. This gene encodes a protein that is part of the FAM115 family, which is involved in various cellular processes, including signal transduction, cellular growth, and maintenance. While detailed functional studies on FAM115C are limited, proteins in this family are often characterized by their involvement in cellular homeostasis and regulatory mechanisms. Research on FAM115C is nascent, but it is suggested to play a role in the central nervous system based on expression patterns in brain tissues.
仅用于科研。不用于诊断过程。未经明确授权不得转售。
篇参考文献 (0)
生物信息学
蛋白别名: family with sequence similarity 115, member C; family with sequence similarity 139, member A; protein FAM115C; TRP channel-associated factor 2; TRPM8 channel-associated factor 2; unnamed protein product
基因别名: FAM115C; FAM139A; GATD9; GATD9B; TCAF2
UniProt ID: (Human) A6NFQ2
Entrez Gene ID: (Human) 285966